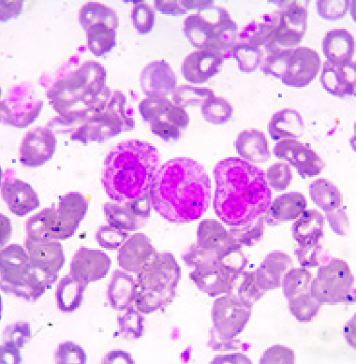
Targeted elimination of leukemic stem cells

ANU makes major investment in student safety
The Australian National University (ANU) has today announced a multi-million dollar investment to accelerate action to tackle sexual assault and sexual harassment in its community.
Honouring passion and perseverance at the NUS Achievement Awards 2024
The second iteration of the NUS Achievement Awards (NAA), held on 26 October 2024 at the University Cultural Centre, brought together students...
An extrasolar world covered in water?
With the help of instruments designed partly in Canada, a team of Université de Montréal astronomers have discovered an exoplanet that could be completely covered in water.
Ninety speakers discuss innovation in higher education amid pandemic at LU Conference for Higher...
Lingnan University (LU) hosted the annual Conference for Higher Education Research (CHER) 2020 On 13 and 14 November, offering the education sector a chance to take stock of the valuable lessons...
Microscopes and computers join forces to unravel biological mysteries
Researchers at the NUS Centre for BioImaging Sciences (CBIS) have developed a new method to observe materials of low atomic weight, such as biological molecules...
CityU secures HK$23m funding from two RGC Research Fellow Schemes
City University of Hong Kong (CityU) has been granted more than HK$23 million in research funding from the inaugural Senior Research Fellow Scheme (SRFS)...
The handbag – a contemporary marketplace icon
Source: School of Business, Aalto University (Finland)
Phone, tissues, wallet, pen and keys. These daily necessities – and many...
University of Adelaide Year 11 Pathway Extended for 2020 Intake
Year 12 students in South Australia and some interstate will have the option of using their Year 11 results to gain entry to the University of Adelaide for study in 2022.
$2.5 million to improve health of First Nations families
A program that is already showing unprecedented success in improving the health and employment outcomes of First Nations families has been awarded $2.5 million...
Potential new biomarker for depression and bipolar disorder
UniSA scientists have developed the world’s first test to accurately predict mood disorders in people, based on the levels of a specific protein found in the brain.